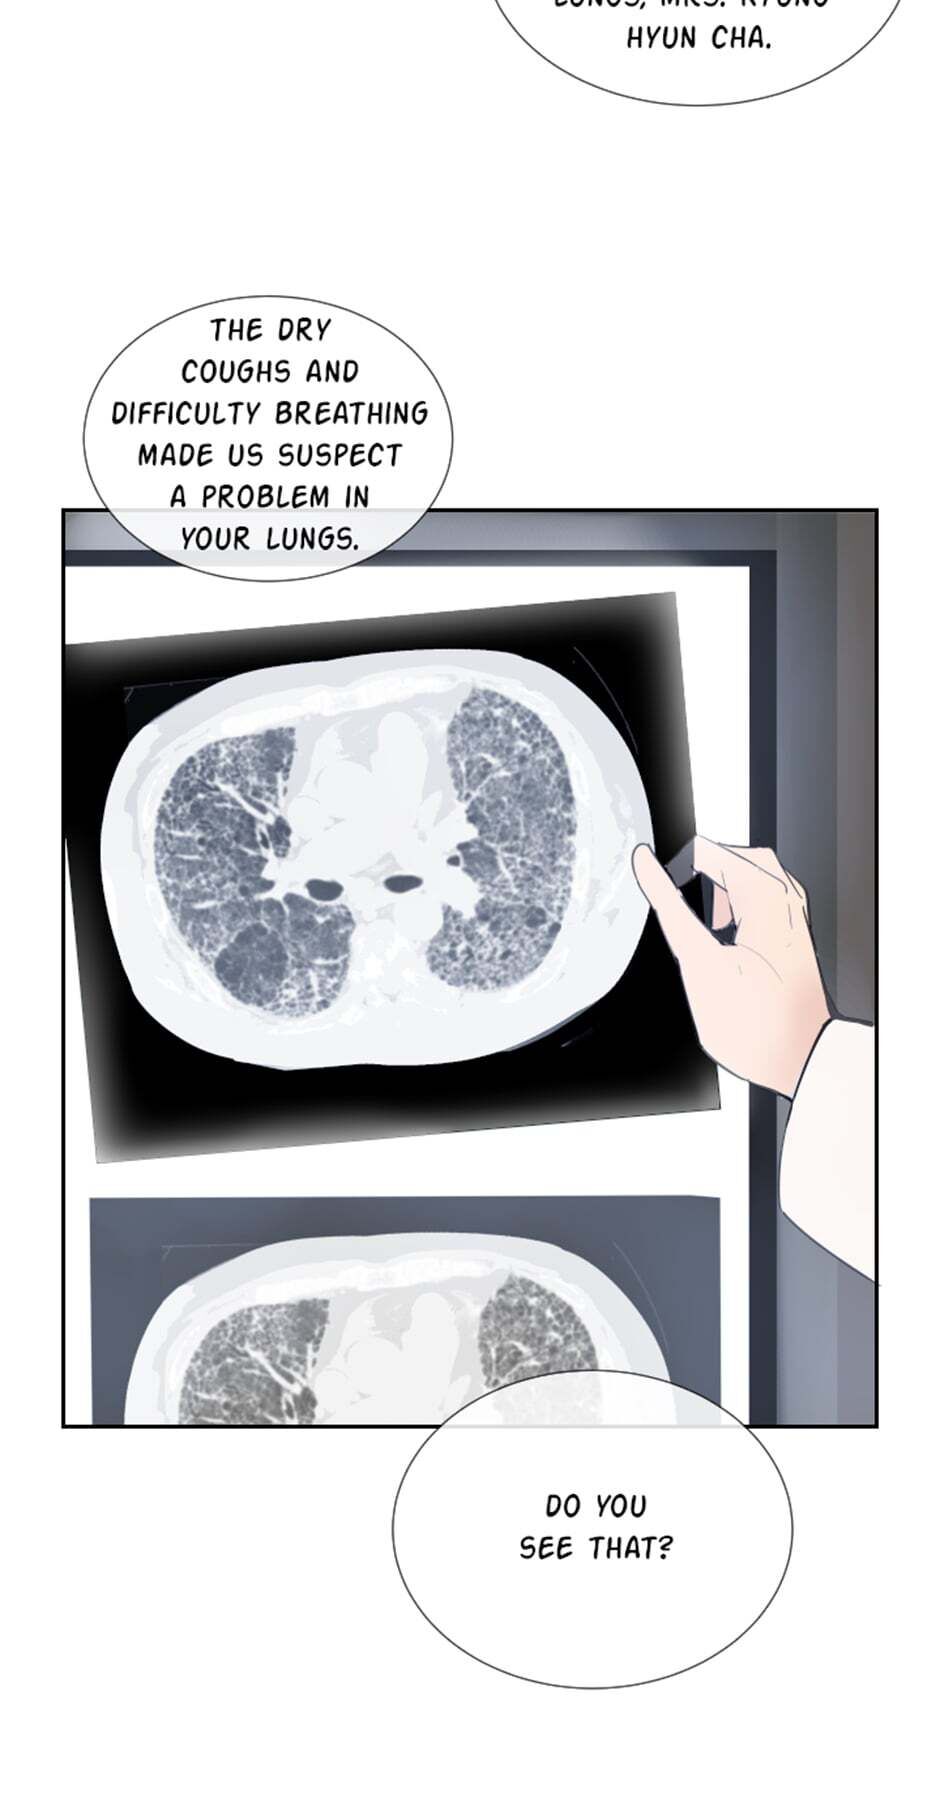

Devil Sword King - Chapter 126
NEW MANGA UPDATES
Tags:
A Trivial Extra in a Dating Sim, Cinderella Wasn't Me, Circumstances of Switching Bodies, Comics book, Devil Sword King, Divorce Me, Divorce Me Husband!, Elizabeth, Even Though I’m the Villainess, Fantasy, Finding Camellia, Flower Is Not Full, Grand Duke, Grand Duke It Was a Mistake!, Hotmanga, How to Clear a Dating Sim as a Side Character, Hua Kai Wei Man, Husband!, I Am Not Healthy, I Didn't Mean to Seduce the Male Lead, I Have No Health, I Only Came to Find my Dad, I Wasn't Cinderella, I'm a Princess?, I’ll Be The Matriarch In This Life, Idiot Abella, It all starts with playing game seriously, It Was a Mistake!, Manga Hot, manga new, Manga Trending, Manganew, Manhwa-s2manga, Please Be Patient, Princess’s Doll Shop, s2manga, s2manga-Trending, Starting from Today, Starting from Today I'm a Princess?, Sword Sheath’s Child, The Half-Open Flower, The Princess' Doll Shop, The Reason Why Ophelia Can’t Get Away From The Duke, There Were Times When I Wished You Were Dead, This Wish Is Cancelled, Trending-s2manga, TVNT, Under the Oak Tree, Why Ophelia Can't Leave the Duke's Family, Why She Lives as a Villainess, 남편님!, 니웨 작가님 / Hampig 작가님, 단청, 대공님, 대공님 실수였어요, 라지에르의 서, 레이디 스칼렛, 레이지피스, 몸이 바뀌는 사정, 미연시게임 속 하찮은 엑스트라, 백치 아벨라, 솔티, 신데렐라는 내가 아니었다, 실수였어요, 아빠만 찾으려고 했는데, 오늘부터 황녀?!, 오필리어가 공작가를 벗어나지 못하는 이유, 이 소원을 취소, 이혼해주세요, 참아주세요, 칼집의 아이, 황녀님의 인형가게